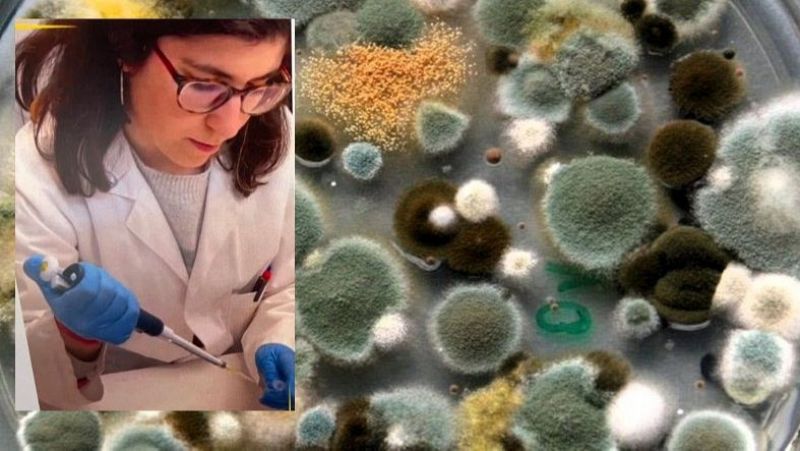

🎓🧠 ¡Gracias a los 70 alumnos y alumnas que han participado en la 4ª edición del #cursodeveranoTCES “La aventura de divulgar ciencia en español con éxito”!
📍Palacio de la Magdalena, UIMP.
📸 Las sonrisas lo dicen todo: fueron tres días emocionantes.

🎓🧠 ¡Gracias a los 70 alumnos y alumnas que han participado en la 4ª edición del #cursodeveranoTCES “La aventura de divulgar ciencia en español con éxito”!
📍Palacio de la Magdalena, UIMP.
📸 Las sonrisas lo dicen todo: fueron tres días emocionantes.

🧪🪐 La aventura de divulgar ciencia en español con éxito #cursodeveranoTCES
Charla magistral de @gmarfanyn.bsky.social, catedrática de genética en @geneticsub.bsky.social @ub.edu: ¿Mejoraremos genéticamente a la especie humana?

Palacio de las Caballerías, Santander

Mesa redonda de comunicadores científicos

Taller sobre charlas divulgativas

Selfie en la Península de la Magdalena
Esta semana estoy en Santander, en el curso de comunicación científica organizado por @theconversation.com en la Península de la Magdalena.
En el primer día, tuvimos charlas de gente tan buena como @gmarfanyn.bsky.social y un taller increíble de presentaciones divulgativas ✨


¡Hoy es el día! Comienza nuestro #CursoDeVeranoTCES en la UIMP! Mira el programa completo de estos días:
09.07.2025 07:15 — 👍 2 🔁 2 💬 0 📌 0
Los mohos suelen proliferar en lugares húmedos de nuestras casas y en alimentos en mal estado. Pero los hay muy beneficiosos para la industria y el medio ambiente. De eso he estado hablando en #MasCerca www.rtve.es/play/audios/...
05.06.2025 14:37 — 👍 0 🔁 0 💬 0 📌 0
Desde el primer “match” de los hongos hasta por qué son un partidazo para la biotecnología… y también una amenaza que suena a "The Last of Us", pero tiene poco de ciencia ficción.
Podéis ver mi charla completa aquí: Hongos, ni contigo ni sin ti 💔
www.twitch.tv/videos/24476...

Mañana en el Pub Big Beng (Valencia) estaré hablando sobre nuestra “difícil” relación con los hongos. Podéis verlo en directo o por Twitch en el canal de Moebius Ciencia 🤗
30.04.2025 22:06 — 👍 0 🔁 0 💬 0 📌 0
Ayer se publicó en el @abc_es un interesante artículo sobre el papel de la biotecnología en la sostenibilidad para mejorar la industria textil 🧥♻️
¡Gracias a Laura Montero por invitarme a participar! Podéis leer el artículo aquí ⬇️
www.abc.es/economia/inn...

Unos colegas van a lanzar HIDALGO - un juego cooperativo ambiental en el mundo de don quijote. Si podéis y os mola la idea, echale un backing @Kickstarter www.kickstarter.com/projects/inf...
25.03.2025 21:26 — 👍 27 🔁 29 💬 1 📌 1
#Voces11F en su Temporada 5. Presenta a las 🌟 Ganadoras #Cuéntame11F
El 2° episodio entrevista a Laura Rojo Guerrero , Bárbara Castillo-Abdul y Carolina Ropero Pérez @carolinarp.bsky.social
Conoce su fascinante trayectoria, su motivación, sus desafíos 👩🔬🧪🦸♀️
#11F2025
Hace unos meses fui seleccionada ganadora en el concurso de divulgación #Cuéntame11F 📽️
Ahora podéis escuchar un poquito más sobre mi y el resto de las ganadoras en el último podcast de #Voces11F ¡No os lo perdáis! 😉⬇️

Seguro que habréis oído hablar que George Church y la empresa #Colossal que cofundó quieren desextinguir el mamut lanudo. De momento han conseguido crear ratones con variantes genéticas del mamut: un rarón lanudo. Increíble!
Lo explico en @sciencemediacentre.es
sciencemediacentre.es/crean-ratone...

El doctorado es la fase más precaria de la carrera investigadora, hecha muchas veces sin ni siquiera contrato.
Participamos junto con @ointegridadesp.bsky.social en este artículo de @elespanol.com con declaraciones de @cristrinaranjus.bsky.social y Daniel Lumbreras.
www.elespanol.com/ciencia/2025...

First day in Dublin for the #ECFG17 congress ☘️🇮🇪 You can check my poster about the mode of action of the PeAfpA antifungal protein against P. digitatum through transcriptomics analysis 🧬 @iatacsic.bsky.social @FungalFact
03.03.2025 14:32 — 👍 4 🔁 0 💬 0 📌 0
En mi canal de #YouTube tenéis un montón de vídeos con muchas de mis conferencias científicas (en castellano y en inglés), charlas divulgativas, entrevistas, comentarios y presentaciones de libros, y mis vídeos del #BIOTENTE
youtube.com/@lluis.monto...

Suavizantes, antimanchas, antiarrugas, colorantes… son compuestos que se añaden a los tejidos y no siempre resultan saludables para el organismo humano y para el medioambiente. ¿Cómo podemos evitarlos?

El moho, de enemigo del hogar a motor de innovación
theconversation.com/el-moho-de-e...